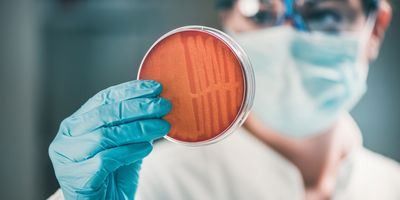
Researcher, wearing gloves, holding a petri dish with bacteria growing on it

superbugs
Superbug Develops Fast Resistance to “Last Resort” Antibiotic
University of Oxford
New research has found that Pseudomonas bacterium develops resistance much faster than usual
Innovative Screening Method Finds Rifabutin Can Fight Acinetobacter baumannii Superbug
Today's Clinical Lab
Researchers designed a new type of nutrient-limited media that better mimics conditions inside the body